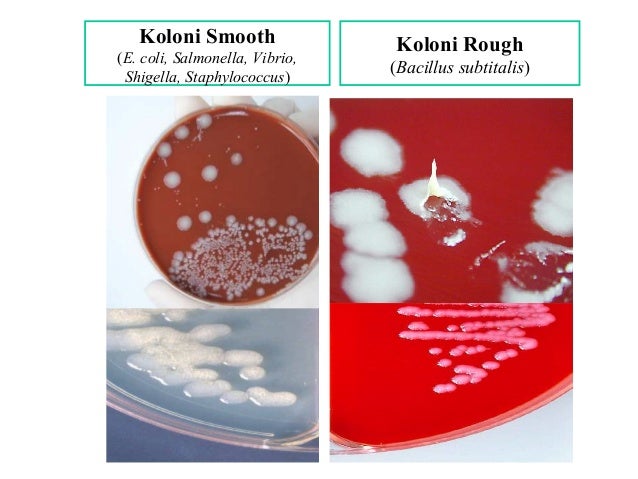

5+ Bentuk Bentuk Bakteri
Agustus 06, 2021
identifikasi bentuk bentuk bakteri pada gambar, sebutkan bentuk bentuk bakteri, bentuk bakteri diplokokus, bentuk bakteri spiral, sebutkan bentuk bentuk bakteri dan berikan contohnya, jelaskan bentuk bentuk bakteri, membuat gambar bentuk bentuk bakteri, bentuk bentuk bakteri basil,
5+ Bentuk Bentuk Bakteri - Mempunyai mushola minimalis tentu sangat membingungkan semisal anda tidak memliki pandangan khusus , akan tetapi jika di rancang dengan hebat tak bisa di pungkiri, Bentuk Bentuk Bakteri anda akan menjadi menyegarkan. Penampilan yang elok dan elegan, mungkin tak sedikit dana yang harus anda keluarkan. Asal anda bisa memiliki ide, inspirasi dan konsep gaya yang cemerlang, tentunya akan banyak irit anggaran.
Untuk itulah simak penjelasan terkait mushola minimalis agar rumah yang anda tempat menjadi nyaman, tentunya dengan desain dan model sesuai dengan idaman keluarga Anda.Berikut yang kami sampaikan tentang mushola minimalis dengan judul 5+ Bentuk Bentuk Bakteri.

Health and Fitness 2 Avoiding Germs ar Workout Facility Sumber Gambar : www.pinterest.com
Bentuk Bakteri Pengertian Contoh Dan Gambarnya
Bentuk Bentuk Bakteri Ukuran bakteri umumnya dinyatakan dalam satuan micron dimana 1 mikron sama dengan 0 001 mm atau 1 mm dibagi 1000 Satuan ini sengaja digunakan untuk memudahkan pengucapan ukuran bakteri yang memang sangat kecil Secara umum bakteri memiliki panjang antara 0 5 sampai 3 mikron dan lebar antara 0 1 sampai 0 2 mikron

ApaAjaLah Entamoeba gingivalis Sumber Gambar : blogonengs.blogspot.com
Bentuk Bakteri Pengertian Ciri Faktor Dan
Bentuk Bakteri Apa Itu Bakteri Kata bakteri bersal dari bahasa latin yang artinya bacterium jamak atau tunggal yang merupakan Bentuk Bentuk Bakteri Bentuk bakteri coccus merupakan bakteri yang mempunyai bentuk bulat atau bujur seperti bentuk Ciri Ciri Bakteri Terdapat beberapa ciri

Morfologi Sifat Gram Ciri ciri BAKTERI DOCLOL Sumber Gambar : doclol.blogspot.com
Ciri Ciri Bakteri Klasifikasi Struktur Bentuk Macam
Bentuk Bakteri Bentuk dasar bakteri terdiri atas bentuk bulat kokus batang basil dan spiral spirilia serta terdapat bentuk antara kokus dan basil yang disebut kokobasil

ILMU PETERNAKAN PERTANIAN DAN MAMFAATNYA BAGI DUNIA Sumber Gambar : ilmupeternakandanpertanian.blogspot.com
Bakteri Pengertian Bentuk Contoh Dan
18 10 2022 · Bentuk Bentuk Bakteri Ukuran bakteri umumnya dinyatakan dalam satuan micron dimana 1 mikron sama dengan 0 001 mm atau 1 mm dibagi 1000 Satuan ini sengaja digunakan untuk memudahkan pengucapan ukuran bakteri yang memang sangat kecil Secara umum bakteri memiliki panjang antara 0 5 sampai 3 mikron dan lebar antara 0 1 sampai 0 2 mikron
Manipulasi sel pada kultur Sumber Gambar : www.slideshare.net
3 Bentuk Umum Bakteri
Bakteri ini memiliki bentuk yang berbeda beda dan disebut pleomorfik mereka memiliki bentuk yang berbeda pada titik yang berbeda dalam siklus hidupnya Bentuk bakteri tidak biasa lainnya termasuk bentuk bintang bentuk klub bentuk kubus dan cabang berserabut

Kesuburan Tanah Kelas B Unsur hara dan fungsinya pada Sumber Gambar : kesuburankelasb.blogspot.com
Bentuk Bentuk Bakteri good mood
Bentuk bakteri terdiri dari 3 macam yaitu Bentuk Batang Basil Bentuk Bulat Kokus Bentuk Spiral Bakteri berbentuk batang basil dibedakan sebagai berikut Basil tunggal berupa batang tunggal Contoh Escherichia coli dan Salmonella typhi Diplobasil berbentuk batang bergandeng dua dua Contoh Renibacterium salmoninarum Sreptobasil berupa batang bergandengan rantai Contoh Azotobacter

bioloFREAK EUBACTERIA ARCHAEBACTERIA Sumber Gambar : oursbiolofreak.blogspot.com
Macam Macam Bentuk Bakteri Beserta Gambar dan
Bakteri Wujud Basil Sel kuman bakteri berupa silindris semacam batang Akhir sel bermacam macam semacam persegi bulat meruncing serta serupanya Kuman berupa batang bisa ditemui dalam kondisi tunggal monobasilus berduaan diplobasilus ataupun koloni yang membuat kaitan steptobasilus Lukisan serta uraian ketiga wujud kuman bakteri itu merupakan bagaikan selanjutnya lukisan macam macam wujud kuman bakteri

Colibacillosis Sumber Gambar : www.slideshare.net
Ciri Ciri Bakteri Ukuran Bentuk Koloni dan Struktur
B Bentuk Bakteri 1 Basil Basil atau batang adalah bentuk salah satu bentuk bakteri yang paling sering kita amati di buku pelajaran 2 Kokus Bentuk bakteri selanjutnya adalah bulat atau kokus Bentuknya seperti bola contohnya adalah Nitrosococcus 3 Spirilum Bentuk bakteri terakhir yang
identifikasi bentuk bentuk bakteri pada gambar, sebutkan bentuk bentuk bakteri, bentuk bakteri diplokokus, bentuk bakteri spiral, sebutkan bentuk bentuk bakteri dan berikan contohnya, jelaskan bentuk bentuk bakteri, membuat gambar bentuk bentuk bakteri, bentuk bentuk bakteri basil,
otoymarotoy Manifestasi HIV Terhadap Mulut Sumber Gambar : otoymarotoy.blogspot.com
Pelajari Bentuk Bakteri Pengertian Ciri ciri Bentuk
Bentuk Bakteri Pada umumnya bentuk bakteri terdiri dari tiga macam bentuk 1 Bulat

Praktikum Mikologi Pemeriksaan Jamur Penyebab Mikosis Sumber Gambar : www.referensibiologi.com
Bentuk Bakteri Macam Macam Gambar dan
Bakteri spirillum berbentuk panjang dan lengkung menyerupai spiral berkelok atau melengkung Biasanya bakteri bentuk ini hidup soliter tidak membentuk koloni Meskipun bentuk dasarnya sama tiap jenis bakteri spirilum mempunyai perbedaan dalam hal panjang jumlah lekukan panjang lekukan dan kerapatan lekukan Berdasarkan perbedaan perbedaan tersebut bakteri spirilum dibedakan menjadi
Jenis serta Cara Mengelola Sampah Organik dan Anorganik Sumber Gambar : blog.elevenia.co.id

ardi sanjaya PEWARNAAN GRAM Sumber Gambar : ardiunikal.blogspot.com

Monera dan Kehidupannya Your Daily Basis Sumber Gambar : akwh-notes.blogspot.com
Aridhoprahasti Education Blog PRAKTIKUM PENGAMATAN JAMUR Sumber Gambar : aridhoprahasti.blogspot.com